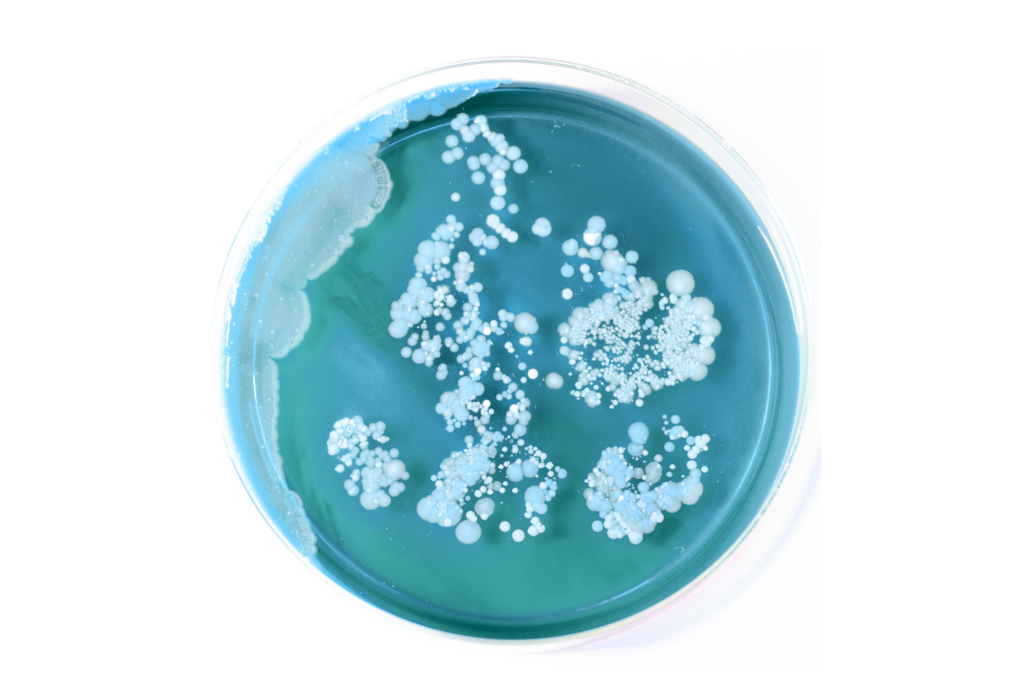
Petri dish with blue agar medium and white bacterial colonies growing on the surface

There’s a wealth of information that can be found on the label of a probiotic. You may be used to seeing MILLIONS and BILLIONS plastered all over, but what do these numbers mean? And how are they measured?

When choosing a supplement (let’s say a vitamin C supplement, for instance), you likely look at measurements like dosage (in milligrams) or percent Daily Value (%DV) to determine how much of that nutrient is in each serving and make an informed decision based on your specific needs.
For probiotics, there are also measurements that can tell you more about what you’re consuming. The number of viable microbial cells contained in a serving is a valuable piece of information, often measured in CFU, or Colony-Forming Units. While it may be tempting to gravitate towards the label with the biggest number, that doesn’t always mean better results. The best dose, per strain, is the one that has been studied in humans and shown to deliver positive outcomes, i.e. impart a health benefit(s). (In fact, this is an important component of the scientific definition of a probiotic.)
In addition to the dosage itself, the method of measurement is an equally (if not more) important consideration. Most probiotics use CFU to enumerate the number of viable bacteria in the product. However, while CFU remains the industry standard, it is not an exact science, and there is another, more precise, alternative—AFU, or Active Fluorescent Units. To better understand the differences in these measurements, let’s explore what they are and how they work.
CFU represents the number of bacteria in a sample that are capable of dividing and forming colonies. The technique used to determine CFU count is a classic microbiology technique that has been used since the 1800s, known as plating, in which a single bacteria replicates itself over and over until there are so many cells that they are visible to the naked eye.
The white dots seen on the plate above are colonies of bacteria.
Then, by counting the number of visible colonies, the number of live and multiplying bacteria in the original sample can be calculated. Each “unit” represented by the CFU value refers to a single replicating bacteria. So when it comes to probiotics, 1 billion CFU would indicate an estimated 1 billion bacteria within each serving.
CFU operates on the convention that viable microbes must be capable of forming colonies, which excludes live microbes that have adapted to environmental stress by becoming dormant. These are referred to as viable but not culturable (VBNC) cells. CFU can also vary widely between batch lots, and it is ineffective for multi-strain probiotics, as different strains of bacteria require different growth media. So, what is the alternative?
Instead of CFU, probiotics can be tested for AFU (Active Fluorescent Units), an advanced and more precise method for cell enumeration. This technique uses flow cytometry tests, a high-tech process for counting viable microorganisms by laser. Flow cytometry is a process where cells (in our case, probiotic cells) are tagged with fluorescent “markers” that indicate their integrity and viability. Those fluorescent markers are illuminated by a laser as the cells pass individually through a tube. Detectors count the markers on and in each cell, and give a readout of how many microbes in the sample are live and active.

At Med-Lock, we use flow cytometry to measure AFU for both our DS-01™ Daily Synbiotic and PDS-08™ Pediatric Daily Synbiotic. In this way, we are able to calculate a more precise measurement of all viable cells, including ones that are viable but not necessarily culturable (and therefore would not be counted in a CFU measurement).
This helps ensure that our product actually lives up to its claims, and can be validated in rigorous scientific research. When tested in a double-blind, randomized, placebo-controlled study, DS-01® Daily Synbiotic supported comfortable and regular bowel movements in people with occasional digestive discomforts.1*
Deciding on a probiotic isn’t always easy. There are many factors to consider when it comes to choosing a quality product, and it isn’t as simple as picking the probiotic with the highest CFU. The method of viable cell measurement is one important quality to look out for to better understand exactly how many live and viable microorganisms are contained within each serving. For more additional considerations and guidance, see here.
- Napier, B. A., Van Den Elzen, C., Al-Ghalith, G. A., Avena, C. V., Gevers, D., Dhir, R., Nee, J., Lembo, A., & Simmons, S. L. (2024). MO1894 A MULTI-SPECIES SYNBIOTIC (DS-01) ALLEVIATES CONSTIPATION AND ABDOMINAL PAIN IN IRRITABLE BOWEL SYNDROME SUBTYPE MIXED (IBS-M) SUBJECTS WHILE BOOSTING SYNBIOTIC SPECIES ASSOCIATED WITH DECREASED SYSTEMIC INFLAMMATION AND NET FORMATION. Gastroenterology, 166(5), S-1164. https://doi.org/10.1016/s0016-5085(24)03133-0



















